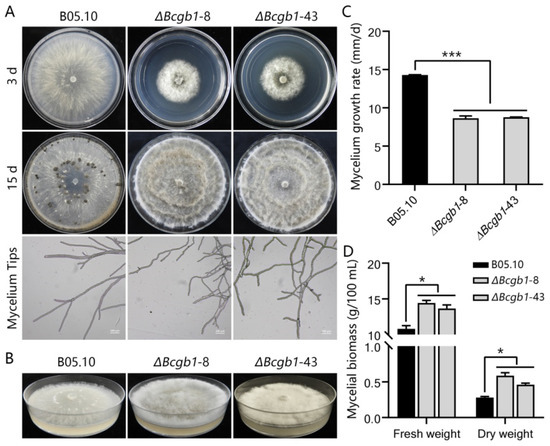

Abstract
Botrytis cinerea is a necrotrophic phytopathogenic fungus that causes gray mold disease in many crops. To better understand the role of G protein signaling in the development and virulence of this fungus, the G protein β subunit gene Bcgb1 was knocked out in this study. The ΔBcgb1 mutants showed reduced mycelial growth rate, but increased aerial hyphae and mycelial biomass, lack of conidiation, failed to form sclerotia, increased resistance to cell wall and oxidative stresses, delayed formation of infection cushions, and decreased virulence. Deletion of Bcgb1 resulted in a significant reduction in the expression of several genes involved in cAMP signaling, and caused a notable increase in intracellular cAMP levels, suggesting that G protein β subunit Bcgb1 plays an important role in cAMP signaling. Furthermore, phosphorylation levels of MAP kinases (Bmp1 and Bmp3) were increased in the ΔBcgb1 mutants. Yeast two-hybrid assays showed that Bcgb1 interacts with MAPK (Bmp1 and Bmp3) cascade proteins (BcSte11, BcBck1, BcMkk1, and BcSte50), and the Bmp1-regulated gene Bcgas2 was up-regulated in the ΔBcgb1 mutant. These results indicated that Gβ protein Bcgb1 is involved in the MAPK signaling pathway in B. cinerea. In summary, our results revealed that Gβ protein Bcgb1 controls development and virulence through both the cAMP and MAPK (Bmp1 and Bmp3) signaling pathways in B. cinerea.
1. Introduction
Botrytis cinerea is an important phytopathogenic fungus and the causal agent of gray mold disease in more than 1400 plant species. It is responsible for significant economic losses in many important vegetables, fruits, and ornamentals [1]. The cost of controlling gray mold disease in the world has been estimated at over €1 billion per year. Due to its scientific and economic importance, B. cinerea is considered as the second most important fungal pathogen and the necrotrophic model fungus [2]. In the life cycle of B. cinerea, there are four different structures, including conidia, mycelia, sclerotia, and ascospores. Since sexual ascospores rarely occur in nature, the main source of the initial inoculum in the field is asexual conidia that formed from germinating sclerotia or hyphae, or survived in the last season [3]. Sclerotia are the melanized dormancy structures that can survive in adverse environment. When favorable conditions appear in spring, sclerotia will germinate to produce hyphae and conidia as the source of initial infection. Therefore, sclerotia and conidia play pivotal roles in the epidemic and life cycle of B. cinerea [3].
Heterotrimeric G proteins, which consist of Gα, Gβ, and Gγ subunits, transmit a variety of extracellular signals received by membrane-spanning G protein coupled receptors (GPCR) to intracellular effectors of eukaryotic cells [4]. When GPCR senses external signal stimulation, it triggers GDP-GTP exchange in Gα, leading to the dissociation of G protein complex as Gα-GTP and Gβγ dimer. Both Gα-GTP and Gβγ dimer can activate and regulate downstream signaling pathways, such as the cAMP and MAP kinase pathways [4,5].
In filamentous fungi, G proteins have been demonstrated to be required for growth, differentiation, mating, sporulation, and pathogenesis [4]. Like most characterized filamentous fungi, the plant pathogen Magnaporthe oryzae contains three Gα subunit genes (magA, magB, and magC); one Gβ subunit gene, mgb1; and one Gγ subunit gene, MGG1. Three Gα subunit genes are involved in M. oryzae mating, but only magB (group I), like mgb1 and MGG1, is required for appressorium formation and virulence [6,7,8]. In the soilborne vascular wilt fungus Fusarium oxysporum, deletion mutants of the Gα subunit Fga1 (group I) and the Gβ subunit Fgb1 displayed the similar phenotypes, i.e., altered colony morphology, reduced virulence and conidiation, and increased heat resistance [9,10]. However, deletion of the group III Gα subunit Fga2 results in some phenotypes different than those of Fga1 and Fgb1 mutants, such as complete loss of pathogenicity, no alteration on colony morphology, and conidiation [11]. Mutants lacking Fga1 or Fgb1 exhibit reduced intercellular cAMP levels, suggesting that Gα subunit Fga1 and Gβ subunit Fgb1 are involved in the cAMP signaling pathway [9,10]. In another soilborne vascular wilt fungus, Verticillum dahliae, the Gβ subunit gene VGB positively regulates virulence and negatively regulates conidiation and microsclerotia formation [12].
In B. cinerea, the function of three Gα subunit genes (Bcg1, Bcg2, and Bcg3) has been demonstrated by targeted gene deletion, suggesting that all of them are involved in the infection process. The Bcg1 deletion mutants show altered colony morphology and significantly reduced virulence [13,14]. In contrast, deletion of Bcg2 only results in a slight decrease in pathogenicity [13]. The third Gα subunit, Bcg3, is important for conidiation, conidial germination, and virulence [15]. ΔBcg1 and ΔBcg3 mutants show reduced intercellular cAMP levels and their defects are partially restored by exogenous cAMP, implying that Bcg1 and Bcg3 are the upstream components of cAMP signaling pathways. Although the Gα subunits of B. cinerea have been investigated comprehensively, the functional role of the Gβ subunit in growth, conidiation, sclerotia formation, and pathogenicity, as well as its downstream signaling pathway in B. cinerea, is still unclear.
In this study, we knocked out the Gβ subunit gene Bcgb1 using the split-marker strategy. The ΔBcgb1 mutants exhibited defects in mycelial growth, conidiation, sclerotia formation, and virulence. Deletion of Bcgb1 affected intracellular cAMP levels and the phosphorylation level of MAP kinases (Bmp1 and Bmp3). Yeast two-hybrid assays showed that Bcgb1 directly interacts with Bmp1 upstream kinase BcSte11, Bmp3 upstream kinases BcBck1 and BcMkk1, and the BcSte11/BcSte7/Bmp1 MAP kinase adaptor protein BcSte50. Moreover, the qRT-PCR result showed that Bcgas2, the downstream target gene of Bmp1 [16], was remarkably up-regulated in ΔBcgb1. These results suggest that Gβ protein Bcgb1 is involved in regulation of the development and virulence via both cAMP signaling and MAPK (Bmp1 and Bmp3) signaling in B. cinerea.
2. Materials and Methods
2.1. Fungal Strains and Culture Conditions
The wild-type strain B05.10 and its derived strains, including Bcgb1 gene knockout mutants (ΔBcgb1-8, ΔBcgb1-43, and ΔBcgb1-64), were cultivated on potato dextrose agar (PDA) [17] at 20 °C. The Bcgb1 gene knockout mutants were maintained on PDA amended with 100 μg·mL−1 hygromycin B (Calbiochem, San Diego, CA, USA). For growth experiments, the mutants and B05.10 were grown on PDA at 20 °C. Each plate was inoculated with a 5 mm-diameter mycelial agar plug taken from the edge of a 2-day-old colony. To characterize the growth rate, sclerotia formation, and infection cushion formation, a different strain was cultured in constant darkness. To characterize the sporulation, strains were grown under a 12 h light/dark cycle. To test the mycelial biomass, 10 mycelial plugs (5 mm) of each strain were inoculated into an Erlenmeyer flask (250 mL) containing 100 mL potato dextrose broth (PDB) [17], with three flasks for each strain, and the flasks were shake-incubated at 20 °C and 150 rpm for 2 days. Mycelial biomass of each strain was harvested by paper-filtering, dried at 55 °C for 12 h, and weighed. To evaluate the response of Bcgb1 knockout mutants to abiotic stress, the wild-type strain and Bcgb1 knockout mutants were cultured on PDA medium amended with 1 M NaCl, 1 M KCl, 1 M sucrose, 1 M sorbitol, 0.1 mg/mL SDS, 0.3 mg/mL Congo Red (CR), 0.2 mg/mL CalcoFluor White (CFW), and 5mM H2O2. The colony diameters were measured at 72 h to calculate the relative mycelial growth rate of each strain. Each experiment was repeated three times.
2.2. Disruption of Bcgb1
The Bcgb1 gene was disrupted using the split marker method [18]. The disruption strategy for Bcgb1 is showed in Figure S1. The 5′ and 3′ flanking sequences of Bcgb1 were amplified with the primers listed in Table S1 and then fused with part of the hygromycin fragment. Two split-marker DNA fragments were transformed into protoplasts of the WT strain B05.10 using the PEG-mediated transformed technique [19]. The hyphal tips of the deletion transformants were screened on PDA plates containing hygromycin B (100 μg mL−1) three times and verified by PCR. Single spore isolation was performed to obtain the homokaryotic deletion mutants. Three Bcgb1 deletion mutants, ΔBcgb1-8, ΔBcgb1-43, and ΔBcgb1-64, were further confirmed by Southern blot analysis using the right flank of the Bcgb1 gene as a probe. Southern blot analysis was performed by the Gene ImagesTM AlkPhos DirectTM labeling and detection kit from GE Healthcare (Amersham Biosciences, Buckinghamshire, UK).
2.3. Extraction of DNA and RNA
Strains of B. cinerea were grown on PDA medium at 20 °C under darkness for 2 days. Genomic DNA of B. cinerea was extracted from the mycelia using the CTAB method [20]. Total RNA was extracted from mycelium samples of B. cinerea using the RNAiso Plus reagent (TaKaRa, Dalian, China) according to the manufacturer’s instructions.
2.4. Pathogenicity and Penetration Assays
A pathogenicity test was performed with 5-week-old tobacco (Nicotiana benthamiana) leaves using 5 mm mycelial plugs from wild-type, ΔBcgb1-8, and ΔBcgb1-43 mutant strains grown on PDA. Infected leaves were incubated at 20 °C under darkness with 100% relative humidity. The lesion diameters were measured at 72 h post inoculation.
Infection cushions were observed on onion epidermis as per a previous study [21]. Mycelial plugs (5 mm) of each strain were inoculated on onion epidermis and incubated at 20 °C under darkness. The epidermis was sampled and then stained with cotton blue before microscopic examination at 12 h and 24 h post inoculation, respectively. Each experiment was repeated three times.
2.5. Quantification of Intracellular cAMP
Mycelia were harvested from two-day-old PDB [17] liquid cultures, frozen in liquid nitrogen, and lyophilized for 20 h. For every 10 mg of lyophilized mycelium, 1 mL of 0.1 M HCl was added. Samples were centrifuged at 12,000 rpm for 15 min. The supernatant was used to determine cAMP concentration via the Monoclonal Anti-cAMP Antibody Based Direct cAMP ELISA Kit (NewEast Biosciences, Malvern, PA, USA) following the manufacturer’s instructions.
2.6. Reverse Transcription and Fluorescence Quantitative PCR (RT-qPCR)
The cDNA was synthesized via the PrimeScriptTM RT reagent kit (TaKaRa, Dalian, China) according to instructions from the manufacturer. An RT-qPCR was carried out in a CFX96 real-time PCR system (Bio-Rad, Hercules, CA, USA) with TB Green ® Premix Ex Taq™ (Tli RNaseH Plus) (TaKaRa, Dalian, China). The B. cinerea actin gene BcactA (Bcin16g02020) was used as internal control. The relative expression of each gene was evaluated using the ΔΔCT method [22]. All primers used for the RT-qPCR analyses are listed in Table S1. The RT-qPCR assay was repeated three times, each with three biological replicates.
2.7. Assays for Bmp1 and Bmp3 Phosphorylation
Total proteins were isolated from two-day-old mycelia with the protein lysis buffer (50 mM Tris-HCl, pH 7.4, 150 mM NaCl, 1 mM EDTA, 1% Triton X-100) containing 1% each of protease inhibitor cocktail, phosphatase inhibitor cocktail 2, and phosphatase inhibitor cocktail 3 (Sigma-Adrich, St. Louis, MO, USA) as previously described [23]. Then, the total proteins were separated by 10% SDS-PAGE and then transferred to PVDF (polyvinylidene difluoride) membranes (Bio-Rad, Hercules, CA, USA). Phosphorylation of the Bmp1 and Bmp3 MAP kinases was detected by using the phospho-p44/42 MAPK antibody (Cell Signaling Technology, Boston, MA, USA). The total Bmp1 and Bmp3 was detected with anti-MAPK ERK 1/2 antibody (Santa Cruz Biotechnology, Dallas, TX, USA). The anti-GAPDH was used as a loading control.
2.8. Yeast Two–Hybrid Assays
The MatchmakerTM Gold yeast two-hybrid system (Clontech, Mountain View, CA, USA) was used to analyze the protein–protein interactions. The full-length cDNA of Bcgb1 (Bcin08g01420) was cloned into pGADT7 vector. Full-length cDNAs of BcSte11 (Bcin03g02630), BcSte7 (Bcin04g05630), BcBck1 (Bcin02g06590), BcMkk1 (Bcin03g07190), and BcSte50 (Bcin08g03660) were cloned into pGBKT7 vector. A pair of plasmids (pGBKT7-53 and pGADT7-T) served as a positive control and a pair of plasmids (pGBKT7-Lam and pGADT7-T) was used as a negative control. The resulting prey and bait constructs were co-transformed in pairs into yeast strain Y2H following the manufacturer’s instructions. Transformants were grown on SD-Leu-Trp at 30 °C for 3 days, and then transferred to SD-His-Leu-Trp. The resulting yeast cells were further tested for β-galactosidase activities. The primers used in this experiment are listed in Table S1.
3. Results
3.1. Identification and Deletion of the Bcgb1 Gene in B. cinerea
The Bcgb1 gene (Bcin08g01420) encoded a conserved Gβ subunit protein. The Bcgb1 protein (358 amino acids) contained a 7-WD40 repeat domain and shared high amino acid sequence identity with Gβ proteins in Aspergillus nidulans (82.12%), Neurospora crassa (88.83%), Ustilago maydis (67.6%), Rattus norvegicus (64.53%), Cryphonectria parasitica (88.58%), F. oxysporum (89.69%), V. dahliae VGB (88.86%), and M. oryze (88.86%), although had only 37.5% identity with the Gβ subunit gpb1 in Schizosaccharomyces pombe (Figure 1A). Moreover, phylogenetic analysis also showed that Bcgb1 belonged to the same cluster as the Gβ proteins previously reported using Gα proteins as the outgroup (Figure 1C). Among the known Gβ protein in the Protein Data Bank (PDB), the crystal structure of Bcgb1 was predicted by using R. norvegicus Gβ protein (PDB: 7cfm.1.B) as a template (Figure 1B).

Figure 1.
Sequence analysis of Bcgb1 in B. cinerea. (A) Amino sequence alignment of Bcgb1 orthologues. All conversed residues are shown in black and similar residues in grey. The positions of the seven WD repeats are labeled and indicated by arrows. ** means the conserved WD residues in WD repeats. (B) The crystal model of Bcgb1. The Gβ protein of R. norvegicus Gβ (PDB: 7cfm.1.B) was used as the template for the Bcgb1 model at the SWISS-MODEL website. The seven β-propeller blades were numbered. (C) A neighbor-joining tree based on amino acid sequences of Gβ protein in fungi. The following protein sequences were used: XP_018249805 (fgb1), ABE67098 (GBB1), XP_028497849 (VGB), BAC01165 (mgb1), XP_009851210 (gnb-1), XP_024550185 (Bcgb1), XP_001595393 (SS1G_03482), XP_024345016 (SfaD), XP_657685 (sfaD-1), AAO25585 (cgb1), AAD03596 (GPB1), XP_011386498 (bpp1), 5TDH_B (R. norvegicus Gβ protein), NP_014855 (STE4), AAC37501 (gpb1), XP_024548939 (Bcg1), XP_024552854 (Bcg2), and XP_024553380 (Bcg3). Bootstrap values (%) from 1000 replicates of the data are indicated above the nodes. The red dot represents the Gβ protein Bcgb1 of B. cinerea in this study.
To investigate the function of Bcgb1, a ΔBcgb1 knockout mutant was generated by replacing the Bcgb1 gene with a hygromycin-resistance cassette (HPT) (Figure S1A). After PEG-mediated transformation, three ΔBcgb1 mutants (ΔBcgb1-8, ΔBcgb1-43, and ΔBcgb1-64) were obtained through PCR verification (Figure S1B) and further confirmed by Southern blotting analysis (Figure S1C).
3.2. Bcgb1 Is Required for Hyphal Growth, Conidiation, Sclerotia Formation
To determine the role of Bcgb1 in hyphal growth, conidiation, and sclerotia formation, two ΔBcgb1 mutants (ΔBcgb1-8 and ΔBcgb1-43) grown on PDA were compared with the wild-type strain B05.10. Colonies of ΔBcgb1 mutants showed a fluffy, dense aspect; a decreased colony diameter; and dramatically increased aerial hyphae compared to the wild type (Figure 2A,B). Microscopic analysis showed that the ΔBcgb1 mutants produced more branches at the tip of the hyphae than that of the wild type (Figure 2A). After 15 days of incubation on PDA, the wild-type strain produced a large number of conidia and formed sclerotia. However, the ΔBcgb1 mutants were unable to produce conidia and sclerotia (Figure 2A). In comparison with the wild type, the mycelial growth rate of the ΔBcgb1 mutants was significantly reduced (Figure 2C), but the mycelial biomass was increased (Figure 2D). These results indicate that Bcgb1 plays an important role in hyphal growth, conidiation, and sclerotia formation.
Figure 2.
Bcgb1 is required for mycelial growth, conidiation, and sclerotia formation. (A) Colony morphology (3 d and 15 d) and mycelium tips (48 h) of the indicated strains cultured on PDA at 20 ℃. (B) Aerial hyphae growth is increased in the ΔBcgb1 mutants after incubation on PDA for 7 days at 20 °C. (C) Mycelial growth rate of the indicated strains cultured on PDA at 20 °C *** p < 0.001. (D) Mycelial biomass of the indicated strains cultured in PDB at 20 °C for 2 d. * p < 0.05.
3.3. Bcgb1 Is Involved in Response to Cell Wall and Oxidative Stresses
To investigate functions of Bcgb1 in cell-wall integrity, we examined the sensitivity of the ΔBcgb1 mutants to osmotic stress agents NaCl, KCl, sucrose, and sorbitol; cell-wall disturbing agents SDS, CR, and CFW; and oxidative stress H2O2. Our results show that there was no significant difference in relative growth rate between the ΔBcgb1 mutants and wild type when cultured on PDA containing NaCl, KCl, sucrose, sorbitol, and CR (Figure 3). However, the relative growth rate of the ΔBcgb1 mutants significantly increased when cultured on PDA containing SDS, CFW, and H2O2 (Figure 3A,B). These results indicate that Bcgb1 plays a role in response to cell-wall and oxidative stresses.

Figure 3.
Bcgb1 is involved in responses to cell-wall and oxidative stresses. (A) Sensitivity test of strains to salt stress (NaCl or KCl), osmotic stress (sucrose or sorbitol), cell-wall stress (SDS, CR, or CFW), and oxidative stress (H2O2). Strains were incubated on PDA supplemented with 1 M NaCl, 1 M KCl, 1 M sucrose, 1 M sorbitol, 0.1 mg/mL SDS, 0.3 mg/mL CR, 0.2 mg/mL CFW, and 5 mM H2O2 at 20 °C for 72 h. (B) The relative mycelial growth rate of the indicated strains in the presence of various stresses. * p < 0.05.
3.4. Bcgb1 Is Important for Virulence in B. cinerea
To analyze the role of Bcgb1 in pathogenicity, unwounded and wounded tobacco leaves were inoculated with the mycelial agar plugs of ΔBcgb1 mutants. The ΔBcgb1 mutants showed significantly reduced virulence in tobacco leaves (Figure 4A). At 72 hpi, the lesion size of ΔBcgb1 mutants on both unwounded and wounded leaves decreased by more than 50% compared with that of the wild type (Figure 4B). To determine the virulence defects of ΔBcgb1 mutants in detail, we performed a penetration assay on onion epidermis. As show in Figure 4C, the wild-type strain formed numerous infection cushions and successfully penetrated onion cells at 12 hpi and 24 hpi. However, the average number of infection cushions of ΔBcgb1 mutants was much less than that of the wild type (Figure 4D). This revealed that the ΔBcgb1 mutants delayed the formation of infection cushions to penetrate plant cells, resulting in the decrease of virulence. These results show that Bcgb1 is important for infection cushion formation and virulence.

Figure 4.
Bcgb1 is important for virulence in B. cinerea. (A) Pathogenicity test of the indicated strains on unwounded and wounded tobacco leaves. Disease symptoms were photographed at 72 h post inoculation (20 °C). (B) Lesion size caused by the indicated strains in A. (C) Infection cushion formation by mycelium plugs of the indicated strains on onion epidermis at 12 h or 24 h post inoculation (20 °C). IC: infection cushion, IH: infectious hyphae. (D) Quantitative analysis of infection cushions of the indicated strains in C. *** p < 0.001.
3.5. Bcgb1 Is Involved in the Regulation of Intracellular cAMP Levels
To test whether deletion of Bcgb1 affects the cAMP levels in B. cinerea, the intracellular cAMP levels were measured in the hyphae stage of the ΔBcgb1 mutants and wild type. The cAMP levels of two ΔBcgb1 mutants were drastically increased about fourfold and sixfold, respectively, compared to the wild type (Figure 5A).

Figure 5.
Bcgb1 is involved in the regulation of intracellular cAMP levels. (A) Quantitative determination of intracellular cAMP levels in mycelia of the indicated strains cultured in PDB for 2 days. Two biological repetitions with three replicates were assayed. The error bars represent the SD of three replicates. (B) Transcript level of Bac, BcPde1, and BcPde2 in the WT and the ΔBcgb1 mutants of B. cinerea. (C) Transcript level of BcPka1, BcPka2, and BcPkaR in the WT and the ΔBcgb1 mutants of B. cinerea. * p < 0.05, ** p < 0.01, *** p < 0.001.
Due to the cAMP levels having increased in ΔBcgb1 mutants, we further examined the transcript levels of the cAMP signaling pathway-related genes, such as the adenylate cyclase gene Bac, two phosphodiesterase genes (BcPde1 and BcPde2), and three cAMP-dependent protein kinase (PKA) encoding genes (BcPka1, BcPka2, and BcPkaR). Interestingly, the expression of these six genes (Bac, BcPde1, BcPde2, BcPka1, BcPka2, and BcPkaR) was all significantly reduced in the ΔBcgb1 mutants (Figure 5B,C). These results indicate that Bcgb1 is required for maintaining normal cAMP levels in B. cinerea.
3.6. Bcgb1 Plays an Important Role in Two MAPK (Bmp1 and Bmp3) Signaling Pathways
To investigate whether Bcgb1 plays a role in the MAPK (Bmp1 and Bmp3) signaling pathway, we examined the phosphorylation levels of Bmp1 and Bmp3 in ΔBcgb1 mutants with an anti-TpEY antibody. A Western blotting assay showed that ΔBcgb1 mutants were increased in Bmp1 and Bmp3 phosphorylation compared with the wild type (Figure 6A). To further explore the role of Bcgb1 in Bmp1 and Bmp3 phosphorylation, we examined the interaction of Bcgb1 with the components of two MAPK signaling cascades (BcSte11/BcSte7/Bmp1, BcBck1/BcMkk1/Bmp3, and the MAPK adapter protein BcSte50). The results of yeast two-hybrid show that Bcgb1 directly interacted with both Bmp1 cascade protein (BcSte11) and Bmp3 cascade proteins (BcBck1 and BcMkk1). Moreover, Bcgb1 directly interacted with the MAPK adapter protein BcSte50 (Figure 6B).

Figure 6.
Bcgb1 negatively regulates the Bmp1 and Bmp3 MAPK pathway in B. cinerea. (A) Phosphorylation level of MAPK (Bmp1 and Bmp3) in the ΔBcgb1 mutants. Bmp1 and Bmp3 and their phosphorylated proteins were detected using the ERK1/2 and phospho-p44/42 MAPK antibodies, respectively. The intensity of the phosphorylated Bmp1 and Bmp3 band for each strain is relative to that of the Bmp1 and Bmp3 band, respectively. (B) Yeast two-hybrid assay between Bcgb1 and BcSte11/BcSte7/Bmp1 and BcBck1/BcMkk1/Bmp3 cassette. The pGBKT7-53 and pGADT7-T pair of plasmids served as the positive control. The pGBKT7-Lam and pGADT7-T pair of plasmids served as the negative control. Yeast cells were drop-plated on SD-Trp/-Leu/-His with x-α-gal. (C) Transcript level of the Bmp1 MAPK-regulated gene Bcgas2 in the WT and the ΔBcgb1 mutants of B. cinerea. *** p < 0.001.
To test whether deletion of Bcgb1 altered expression of the downstream target genes of Bmp1, we measured the transcript level of a target gene, Bcgas2 [16], in the ΔBcgb1 mutants and wild type. The results of the qRT-PCR show that the Bcgas2 transcript level was significantly increased in the ΔBcgb1 mutants (Figure 6C). Our findings suggest that Bcgb1 plays an important role in the MAPK (Bmp1 and Bmp3) signaling pathway.
3.7. Deletion of Bcgb1 Affects the Expression of Sclerotia Formation-Related Genes
Because ΔBcgb1 mutants lost the ability to form sclerotia, we examined whether Bcgb1 is involved in controlling the expression of sclerotia formation-related genes in B. cinerea. Twelve genes that were confirmed to be related to sclerotia formation were selected to detect the expression in the ΔBcgb1 mutants and wild type by qRT-PCR (Figure 7). Three genes encoding the VELVET complex (BcLaeA1, BcVEL1, and BcVEL2) were differentially affected in the ΔBcgb1 mutants. The expression of BcLaeA1 in ΔBcgb1 mutants was similar to that in wild type. However, in ΔBcgb1 mutants, the transcript level of BcVEL1 was down-regulated, whereas BcVEL2 was up-regulated. The expression of two NADPH oxidases genes (BcNoxA and BcNoxD) was significantly reduced in ΔBcgb1 mutants. Among six melanogenic genes, four genes (Bcbrn2, Bcscd1, Bcsmr1, and Bcpks12) were repressed in ΔBcgb1 mutants. In contrast, other two melanogenic genes (Bcbrn1 and Bcpks13) were overexpressed in ΔBcgb1 mutants. Furthermore, expression of the bZIP transcription factor gene BcAtf1, which is required for sclerotia formation, was decreased in ΔBcgb1 mutants. Taken together, the expression studies suggested that Bcgb1 plays an important role in regulation of sclerotia formation-related gene expression in B. cinerea.

Figure 7.
Transcript level of the sclerotia formation-related genes in the WT and the ΔBcgb1 mutants of B. cinerea. ** p < 0.01, *** p < 0.001.
4. Discussion
In this study, we characterized the function of the Gβ gene Bcgb1 in B. cinerea, which revealed the multifaceted roles of Bcgb1 in development and virulence. To date, the functions of the Gβ gene have already been studied in several plant pathogenic fungi, including C. parasitica [24], M. grisea [7], F. oxysporum [9], Ustilago maydis [25], Cochliobolus heterostrophus [26], F. verticillioides [27], Gibberella zeae [28], and V. dahliae [12]. Interestingly, the Gβ gene in plant pathogenic fungi played varying roles in development and pathogenicity.
Loss of Bcgb1 in B. cinerea caused mutants with a significant decrease in virulence. This is consistent with the function of the Gβ gene in most plant pathogenic fungi, except that the Gβ gene deletion mutants showed a slightly reduced in virulence in U. maydis [25] and F. verticillioides [27]. In B. cinerea, an infection cushion is a special infection structure that is necessary for successful infection of mycelia. The ΔBcgb1 mutant was defective in infection cushion formation, and was responsible for reduced virulence. Similarly, the Gβ gene played a critical role in the infection structure (appressorium) formation and pathogenicity in M. grisea [7] and C. heterostrophus [26].
Deletion of Bcgb1 resulted in altered colony morphology and decreased mycelial growth rate, but increased aerial hyphae and mycelia biomass. Alteration of colony morphology was also presented in the Gβ deletion mutant of F. oxysporum [9] and V. dahliae [12]. In Aspergillus nidulans, the Gβ deletion mutant ΔsfaD showed a significant reduction in mycelial mass, although the growth rate was similar to wild type [29]. Similar to the ΔBcgb1 mutant, more aerial hyphae were also found in the Gβ mutant of M. grisea [7]. In contrast, the Gβ gene cpgb-1 was required for normal aerial hyphae formation in the chestnut blight fungus C. parasitica [24]. In F. verticillioides, the Gβ gene gbb1 was dispensable for mycelial growth and mycelial mass but important for mycotoxin fumonisin B1 production [27]. These results indicate that Gβ in filamentous fungi plays different roles in mycelial growth.
The Gβ gene is required for sporulation in B. cinerea, which was also found in several fungi, such as C. parasitica [24], M. grisea [7], F. oxysporum [9], C. heterostrophus [26], and F. verticillioides [26]. However, the opposite results, that deletion of Gβ gene caused increased conidiation, were observed in A. nidulans [29] and V. dahliae [12]. In addition, the ΔBcgb1 mutants failed to form sclerotia, but the Gβ mutants of V. dahliae enhanced sclerotia formation [12]. It is suggested that the role of Gβ in conidiation and sclerotia formation was opposite in B. cinerea and V. dahliae. The qRT-PCR results revealed that loss of Gβ affected the expression of sclerotia formation-related genes, indicating that Gβ is an upstream regulatory component of these genes.
In filamentous fungi, G proteins are involved in the regulation of cAMP signaling that controls multiple cellular processes, including growth, development, and virulence [4]. Deletion of the Gβ gene resulted in reduced intracellular cAMP levels in N. crassa [30], M. grisea [7], and F. oxysporum [9]. In addition, loss of Gβ caused a decreased in Gα protein levels in C. parasitica [31] and N. crassa [30]. Therefore, Gβ should maintain normal levels of Gα protein, which stimulates adenylate cyclase activity to form cAMP [32]. However, the intracellular cAMP levels were drastically increased in ΔBcgb1 mutants (Figure 5A), indicating that Gβ serves as an inhibitor to suppress the activity of Gα proteins in B. cinerea. The adenylate cyclase (cAMP biosynthesis) and phosphodiesterase (cAMP hydrolysis) are crucial regulators for maintaining the balance of intracellular cAMP levels [33]. In this study, expression of adenylate cyclases gene (Bac) and phosphodiesterases genes (BcPde1 and BcPde2) was significantly reduced in the ΔBcgb1 mutants (Figure 5B). The possible explanation is that Bcgb1 deletion inhibits the transcription of BcPde1 and BcPde2, resulting in increased cAMP levels that may feedback suppress the expression of Bac. Thus, the activities of adenylate cyclase and phosphodiesterase in ΔBcgb1 mutants needs to be further investigated. Another cAMP signaling component is the cAMP-dependent protein kinase (PKA), consisting of two regulatory subunits and two catalytic subunits. In B. cinerea, BcPka1 and BcPka2 belong to a catalytic subunit, and BcPkaR is the regulatory subunit [34]. Deletion mutants of PKA (ΔBcPka1, ΔBcPka2, and ΔBcPkaR) all showed significantly increased intracellular cAMP levels in mycelia, suggesting that the PKA (BcPka1, BcPka2, and BcPkaR) negatively regulates the intracellular cAMP levels in B. cinerea [34]. Similarly, a significant reduction in expression of three PKA genes (BcPka1, BcPka2, and BcPkaR) and increased intracellular cAMP levels were also observed in ΔBcgb1 mutants (Figure 5C).
In Saccaromyces cerevisiae yeast, the Gβ protein Ste4p is required to transfer the pheromone signal to activate the MAPK mating pathway [35]. However, deletion of Gβ gene fgb1 did not affect phosphorylation level of the MAP kinase Fmk1 in F. oxysporum [31]. Our results show that phosphorylation levels of MAP kinases (Bmp1 and Bmp3) were increased in ΔBcgb1 mutants (Figure 6A), supporting the hypothesis that Gβ regulates the MAPK signaling pathway downstream in Cryptococcus neoformans [36] and M. grisea [7]. Yeast two-hybrid assays showed that Gβ protein Bcgb1 directly interacted with MAPK cascade proteins (BcSte11, BcBck1, BcMkk1, and BcSte50) (Figure 6B). This provides evidence that Gβ is involved in the MAPK signaling pathway. Additional evidence is that Bcgas2, the downstream regulated gene of Bmp1 [16], was up-regulated in the ΔBcgb1 mutant. These results suggest that Gβ protein Bcgb1 plays an important role in the regulation of the MAPK signaling pathway in B. cinerea.
Previous studies have demonstrated that deletion of the MAP kinase Bmp1 causes defects in conidia germination, reduces mycelial growth, causes a failure to form sclerotia, and induces a loss of pathogenicity in B. cinerea [37]. Another MAP kinase, Bmp3, is important for growth, conidiation, sclerotia formation, and virulence [38]. Interestingly, the ΔBcgb1 mutants showed similar defective phenotypes, but increased phosphorylation levels of Bmp1 and Bmp3. Maintenance of normal phosphorylation levels of MAPK is critical for the MAPK signaling pathway in eukaryotic cells. Our data indicate that Gβ protein Bcgb1 is required for maintaining normal phosphorylation levels of Bmp1 and Bmp3 in B. cinerea.
In conclusion, this study presents evidence that Bcgb1 not only plays an important role in the cAMP signaling pathway, but also regulates the MAPK signaling pathway. Bcgb1 may function in cross-talks between these signaling pathways. This might explain the defects of the ΔBcgb1 mutant in mycelial growth, conidiation, sclerotia formation, and virulence. These data provide new insight into the multiple functions of the Gβ protein in filamentous fungi. Further studies are necessary to reveal the molecular mechanism of Gβ in regulating the cAMP signaling pathway and MAPK signaling pathway.
Supplementary Materials
The following are available online at https://www.mdpi.com/article/10.3390/jof7060431/s1, Figure S1: Disruption of Bcgb1 in B. cinerea: (A) Schematic diagram indicating the strategy for disruption of Bcgb1 by the homologous recombination event in B. cinerea. HPT, hygromycin phosphate transferase gene, (B) PCR confirmation of disruption of the Bcgb1 gene in different mutants of B. cinerea, and (C) Southern blot confirmation of the disruption of Bcgb1; Table S1: Primers used in this study.
Author Contributions
Conceptualization, J.T. and L.Y.; methodology, J.T., M.W., and J.Z.; software, J.T.; validation, J.T.; formal analysis, J.T. and L.Y.; investigation, J.T. and L.Y.; resources, G.L. and L.Y.; data curation, J.T. and L.Y.; writing—original draft preparation, J.T.; writing—review and editing, G.L. and L.Y.; supervision, G.L. and L.Y.; project administration, M.W., J.Z., and L.Y.; funding acquisition, L.Y. All authors have read and agreed to the published version of the manuscript.
Funding
This research was funded by the Fundamental Research Funds for the Central Universities (grant no. 2662020ZKPY010).
Institutional Review Board Statement
Not applicable.
Informed Consent Statement
Not applicable.
Data Availability Statement
Not applicable.
Acknowledgments
The authors thank Guotian Li (Huazhong Agricultural University) for his kind suggestions.
Conflicts of Interest
The authors declare no conflict of interest.
References
- Elad, Y.; Pertot, I.; Prado, A.M.C.; Stewart, A. Plant hosts of Botrytis spp. In Botrytis-the Fungus, the Pathogen and Its Management in Agricultural Systems; Fillinger, S., Elad, Y., Eds.; Springer: Berlin/Heidelberg, Germany, 2016; p. 6. [Google Scholar]
- Dean, R.; van Kan, J.A.L.; Pretorius, Z.A.; Hammond-Kosack, K.E.; di Pietro, A.; Spanu, P.D.; Rudd, J.J.; Dickman, M.; Kahmann, R.; Ellis, J.; et al. The top 10 fungal pathogens in molecular plant pathology. Mol. Plant Pathol. 2012, 13, 414–430. [Google Scholar] [CrossRef] [PubMed]
- Carisse, O. Epidemiology and aerobiology of Botryris spp. In Botrytis-the Fungus, the Pathogen and Its Management in Agricultural Systems; Fillinger, S., Elad, Y., Eds.; Springer: Berlin/Heidelberg, Germany, 2016; p. 133. [Google Scholar]
- Li, L.; Wright, S.J.; Krystofova, S.; Park, G.; Borkovich, K.A. Heterotrimeric G protein signaling in filamentous fungi. Annu. Rev. Microbiol. 2007, 61, 423–452. [Google Scholar] [CrossRef] [PubMed]
- Cabrera-Vera, T.M.; Vanhauwe, J.; Thomas, T.O.; Medkova, M.; Preininger, A.; Mazzoni, M.R.; Hamm, H.E. Insights into G protein structure, function, and regulation. Endocr. Rev. 2003, 24, 765–781. [Google Scholar] [CrossRef] [PubMed]
- Liu, S.; Dean, R.A. G protein alpha subunit genes control growth, development, and pathogenicity of Magnaporthe grisea. Mol. Plant Microbe Interact. 1997, 10, 1075–1086. [Google Scholar] [CrossRef]
- Nishimura, M.; Park, G.; Xu, J.R. The G-beta subunit MGB1 is involved in regulating multiple steps of infection-related morphogenesis in Magnaporthe grisea. Mol. Microbiol. 2003, 50, 231–243. [Google Scholar] [CrossRef]
- Li, Y.; Que, Y.; Liu, Y.; Yue, X.; Meng, X.; Zhang, Z.; Wang, Z. The putative Gγ subunit gene MGG1 is required for conidiation, appressorium formation, mating and pathogenicity in Magnaporthe oryzae. Curr. Genet. 2015, 61, 641–651. [Google Scholar] [CrossRef]
- Jain, S.; Akiyama, K.; Kan, T.; Ohguchi, T.; Takata, R. The G protein beta subunit FGB1 regulates development and pathogenicity in Fusarium oxysporum. Curr. Genet. 2003, 43, 79–86. [Google Scholar] [CrossRef]
- Jain, S.; Akiyama, K.; Mae, K.; Ohguchi, T.; Takata, R. Targeted disruption of a G protein alpha subunit gene results in reduced pathogenicity in Fusarium oxysporum. Curr. Genet. 2002, 41, 407–413. [Google Scholar] [CrossRef]
- Jain, S.; Akiyama, K.; Takata, R.; Ohguchi, T. Signaling via the G protein a subunit FGA2 is necessary for pathogenesis in Fusarium oxysporum. FEMS Microbiol. Lett. 2005, 243, 165–172. [Google Scholar] [CrossRef][Green Version]
- Tzima, A.K.; Paplomatas, E.J.; Tsitsigiannis, D.I.; Kang, S. The G protein β subunit controls virulence and multiple growth- and development-related traits in Verticillium dahliae. Fungal Genet. Biol. 2012, 49, 271–283. [Google Scholar] [CrossRef]
- Gronover, C.S.; Kasulke, D.; Tudzynski, P. The role of G protein alpha subunits in the infection process of Botrytis cinerea. Mol. Plant Microbe Interact. 2001, 14, 1293–1302. [Google Scholar] [CrossRef]
- Gronover, C.S.; Schorn, C.; Tudzynski, B. Identification of Botrytis cinerea genes up-regulated during infection and controlled by the G alpha subunit BCG1 using suppression subtractive hybridization (SSH). Mol. Plant Microbe Interact. 2004, 17, 537–546. [Google Scholar] [CrossRef]
- Döhlemann, G.; Berndt, P.; Hahn, M. Different signaling pathways involving a G alpha protein, cAMP and a MAP kinase control germination of Botrytis cinerea conidia. Mol. Microbiol. 2006, 59, 821–836. [Google Scholar] [CrossRef] [PubMed]
- Schamber, A.; Leroch, M.; Diwo, J.; Mendgen, K.; Hahn, M. The role of mitogen-activated protein (MAP) kinase signalling components and the Ste12 transcription factor in germination and pathogenicity of Botrytis cinerea. Mol. Plant Pathol. 2010, 11, 105–119. [Google Scholar] [CrossRef] [PubMed]
- Lou, Y.; Han, Y.; Yang, L.; Wu, M.; Zhang, J.; Cheng, J.; Wang, M.; Jiang, D.; Chen, W.; Li, G. CmpacC regulates mycoparasitism, oxalate degradation and antifungal activity in the mycoparasitic fungus Coniothyrium minitans. Environ. Microbiol. 2015, 17, 4711–4729. [Google Scholar] [CrossRef]
- Kershaw, M.J.; Talbot, N.J. Genome-wide functional analysis reveals that infection-associated fungal autophagy is necessary for rice blast disease. Proc. Natl. Acad. Sci. USA 2009, 106, 15967–15972. [Google Scholar] [CrossRef] [PubMed]
- Liu, X.; Xie, J.; Fu, Y.; Jiang, D.; Chen, T.; Cheng, J. The subtilisin-like protease Bcser2 afferts the sclerotial formation, conidiation and virulence of Botrytis cinerea. Int. J. Mol. Sci. 2020, 21, 603. [Google Scholar] [CrossRef]
- Zeng, L.M.; Zhang, J.; Han, Y.C.; Yang, L.; Wu, M.D.; Jiang, D.H.; Chen, W.; Li, G.Q. Degradation of oxalic acid by the mycoparasite Coniothyrium minitans plays an important role in interacting with Sclerotinia sclerotiorum. Environ. Microbiol. 2014, 16, 2591–2610. [Google Scholar] [CrossRef]
- Zhang, L.; Wu, M.D.; Li, G.Q.; Jiang, D.H.; Huang, H.C. Effect of Mitovirus infection on formation of infection cushions and virulence of Botrytis cinerea. Physiol. Mol. Plant Pathol. 2010, 75, 71–80. [Google Scholar] [CrossRef]
- Xu, Y.; Wang, Y.; Zhao, H.; Wu, M.; Zhang, J.; Chen, W.; Li, G.; Yang, L. Genome-wide identification and expression analysis of the bZIP transcription factors in the mycoparasite Coniothyrium minitans. Microorganisms 2020, 8, 1045. [Google Scholar] [CrossRef] [PubMed]
- Zhang, X.; Bian, Z.; Xu, J.R. Assays for MAP kinase activation in Magnaporthe oryzae and other plant pathogenic fungi. In Plant Pathogenic Fungi and Oomycetes; Methods in Molecular Biology; Ma, W., Wolpert, T., Eds.; Humana: New York, NY, USA, 2018; Volume 1848. [Google Scholar] [CrossRef]
- Kasahara, S.; Nuss, D.L. Targeted disruption of a fungal G-protein β subunit gene results in increased vegetative growth but reduced virulence. Mol. Plant Microbe Interact. 1997, 10, 984–993. [Google Scholar] [CrossRef] [PubMed]
- Müller, P.; Leibbrandt, A.; Teunissen, H.; Cubasch, S.; Aichinger, C.; Kahmann, R. The Gβ-subunit-encoding gene bpp1 controls cyclic-AMP signaling in Ustilago maydis. Eukaryot. Cell 2004, 3, 806–814. [Google Scholar] [CrossRef] [PubMed]
- Ganem, S.; Lu, S.W.; Lee, B.N.; Chou, D.Y.T.; Hadar, R.; Turgeon, B.G.; Horwitz, B.A. G-protein β subunit of Cochliobolus heterostrophus involved in virulence, asexual and sexual reproductive ability, and morphogenesis. Eukaryot. Cell 2004, 3, 1653–1663. [Google Scholar] [CrossRef]
- Sagaram, U.S.; Shim, W.B. Fusarium verticillioides GBB1, a gene encoding heterotrimeric G protein β subunit, is associated with fumonisin B1 biosynthesis and hyphal development but not with fungal virulence. Mol. Plant Pathol. 2007, 8, 375–384. [Google Scholar] [CrossRef] [PubMed]
- Yu, H.Y.; Seo, J.A.; Kim, J.E.; Han, K.H.; Shim, W.B.; Yun, S.H.; Lee, Y.W. Functional analyses of heterotrimeric G protein G alpha and G beta subunits in Gibberella zeae. Microbiology 2008, 154, 392–401. [Google Scholar] [CrossRef]
- Rosén, S.; Yu, J.H.; Adams, T.H. The Aspergillus nidulans sfaD gene encodes a G protein β subunit that is required for normal growth and repression of sporulation. EMBO J. 1999, 18, 5592–5600. [Google Scholar] [CrossRef]
- Yang, Q.; Poole, S.I.; Borkovich, K.A. A G-protein beta subunit required for sexual and vegetative development and maintenance of normal G alpha protein levels in Neurospora crassa. Eukaryot. Cell 2002, 1, 378–390. [Google Scholar] [CrossRef]
- Kasahara, S.; Wang, P.; Nuss, D.L. Identification of bdm-1, a gene involved in G protein β-subunit function and α-subunit accumulation. Proc. Natl. Acad. Sci. USA 2000, 97, 412–417. [Google Scholar] [CrossRef]
- Delgado-Jarana, J.; Martínez-Rocha, A.L.; Roldán-Rodriguez, R.; Roncero, M.I.G.; Di Pietro, A. Fusarium oxysporum G-protein subunit Fgb1 regulates hyphal growth, development, and virulence through multiple signaling pathways. Fungal Genet. Biol. 2005, 42, 61–72. [Google Scholar] [CrossRef]
- Sassone-Corsi, P. The cyclic AMP pathway. Cold Spring Harb. Perspect. Biol. 2012, 4, a011148. [Google Scholar] [CrossRef]
- Schumacher, J.; Kokkelink, L.; Huesmann, C.; Jimenez-Teja, D.; Collado, I.G.; Barakat, R.; Tudzynski, P.; Tudzynski, B. The cAMP-dependent signaling pathway and its role in conidial germination, growth, and virulence of the gray mold Botrytis cinerea. Mol. Plant Microbe Interact. 2008, 21, 1443–1459. [Google Scholar] [CrossRef]
- Hoffman, C.S. Except in every detail: Comparing and contrasting G-protein signaling in Saccharomyces cerevisiae and Schizosaccharomyces pombe. Eukaryot. Cell 2005, 4, 495–503. [Google Scholar] [CrossRef]
- Wang, P.; Perfect, J.R.; Heitman, J. The G-protein beta subunit GPB1 is required for mating and haploid fruiting in Cryptococcus neoformans. Mol. Cell. Biol. 2000, 20, 352–362. [Google Scholar] [CrossRef] [PubMed]
- Zheng, L.; Campbell, M.; Murphy, J.; Lam, S.; Xu, J.R. The BMP1 gene is essential for pathogenicity in the gray mold fungus Botrytis cinerea. Mol. Plant Microbe Interact. 2000, 13, 724–732. [Google Scholar] [CrossRef] [PubMed]
- Rui, O.; Hahn, M. The Slt2-type MAP kinase Bmp3 of Botrytis cinerea is required for normal saprotrophic growth, conidiation, plant surface sensing and host tissue colonization. Mol. Plant Pathol. 2007, 8, 173–184. [Google Scholar] [CrossRef] [PubMed]
Publisher’s Note: MDPI stays neutral with regard to jurisdictional claims in published maps and institutional affiliations. |
© 2021 by the authors. Licensee MDPI, Basel, Switzerland. This article is an open access article distributed under the terms and conditions of the Creative Commons Attribution (CC BY) license (https://creativecommons.org/licenses/by/4.0/).